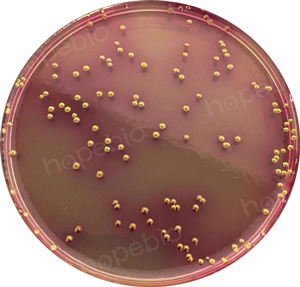
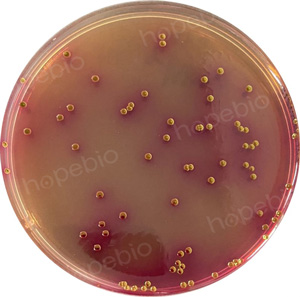

海博微信公众号
海博微信公众号
 海博天猫旗舰店
海博天猫旗舰店


 海博微信公众号
海博微信公众号
 海博天猫旗舰店
海博天猫旗舰店




引言
微生物监测是评估近岸河流水环境质量的重要环节,污水中常含有一定数量的病原微生物,是引发水传播疾病的重要来源。其中较为常见且具有重要影响的包括:沙门氏菌属、志贺氏菌属、粪链球菌、肠道病原性大肠埃希氏菌以及肠道病毒等。
前篇已简述总大肠菌群的概念及多管发酵法的内容,本文将继续介绍另外两种测定总大肠菌群的方法。
对于其他近岸河流水微生物检测的相关内容可参考《近岸河流水域微生物检测-沙门氏菌属的测定》、《近岸河流水域微生物检测-粪链球菌测定多管发酵法》等文章。
一、总大肠菌群的测定—滤膜法
滤膜法所用的是一种微孔性薄膜。将水样注入已灭菌的放有滤膜(孔径0.45 μm)的滤器中,经过抽滤,细菌即被截留在膜上,然后将滤膜贴于品红亚硫酸钠培养基上,进行培养。因大肠菌群细菌可发酵乳糖,在滤膜上出现紫红色具有金属光泽的菌落,计数滤膜上生长的此特性的菌落数,计算出每1 L水样中含有总大肠菌群数。如有必要,对可疑菌落应进行涂片染色镜检,并再接种乳糖发酵管做进一步鉴定。
滤膜法具有高度的再现性,可用于检验体积较大的水样,能比多管发酵技术更快地获得肯定的结果。不过在检验混浊度高、非大肠杆菌类细菌密度大的水样时,有其局限性。
多管发酵法和滤膜法的结果作统计学比较,可显示出后者较为精密。虽然从这两种技术所得到的数据都提供了基本相同的水质情报,但检验结果的数值不同。在做水源水的检验时,可以预期约有80%的滤膜试验的数据落在多管发酵试验数据95%的置信界限内。
1.培养基
(1)品红亚硫酸钠培养基HB0118品红亚硫酸钠琼脂
(2)乳糖蛋白胨培养液HB0119乳糖蛋白胨培养液
(3)乳糖蛋白胨半固体培养基HB8463乳糖蛋白胨半固体培养基
2.步骤
(1)过滤水样
① 滤膜及滤器的灭菌:将滤膜放入烧杯中,加入蒸馏水,置于沸水浴中煮沸灭菌三次,每次15 min,也可使用市面上的无菌滤膜。前两次煮沸后需更换水洗涤2-3次,以除去残留溶剂。也可用121℃灭菌10 min,灭菌后迅速将蒸汽放出,这样可以尽量减少滤膜上凝集的水分。
滤器、接液瓶和垫圈分别用纸包好,在使用前先经121℃高压蒸汽灭菌30 min。
滤器灭菌也可用点燃的酒精棉球火焰灭菌。
② 过滤装置安装:以无菌操作把滤器、接液瓶、缓冲瓶、真空泵依次连接安装。
③ 水样量的选择:待过滤水样量是根据所预测的细菌密度而定的(见表1对总大肠菌群做滤膜试验应过滤水样的参考体积)。
一个理想的水样体积,可以产生大约50 CFU大肠菌群细菌菌落,而全部类别的菌落数则不超过200 CFU。当过滤水样体积少于20 mL时,应在过滤之前加少量的无菌稀释水到过滤漏斗中,以便水量的增加有助于悬浮的细菌均匀分布在整个过滤表面。
④过滤:用无菌镊子夹取灭菌滤膜边缘,将粗糙面向上,贴放在已灭菌的滤床上,稳妥地固定好滤器。将适量的水样注入滤器中,加盖,开动真空泵即可抽滤除菌。
表1对总大肠菌群做滤膜试验应过滤水样的参考体积
|
水样种类 |
过滤体积(mL) |
|||||||
|
100 |
50 |
10 |
1 |
0.1 |
10-2 |
10-3 |
10-4 |
|
|
饮用水 |
√ |
|
|
|
|
|
|
|
|
泳池水 |
√ |
|
|
|
|
|
|
|
|
井水、泉水 |
√ |
√ |
√ |
|
|
|
|
|
|
湖泊、水库 |
√ |
√ |
√ |
|
|
|
|
|
|
供水的进水 |
|
|
√ |
√ |
√ |
|
|
|
|
沙滩浴场 |
|
|
√ |
√ |
√ |
|
|
|
|
河水 |
|
|
|
√ |
√ |
√ |
√ |
|
|
加氯的污水 |
|
|
|
√ |
√ |
√ |
|
|
|
原污水 |
|
|
|
|
√ |
√ |
√ |
√ |
(2)培养
水样抽滤完后,再抽约5 s,关上滤器阀门取下滤器,用灭菌镊子夹取滤膜边缘部分,移放在品红亚硫酸钠培养基上,滤膜截留细菌面朝上,滤膜应与培养基完全贴紧,两者间不得留有气泡。然后将平皿倒置,放入37℃恒温箱内培养24 h。培养期间,保持充足的湿度(大约90%相对湿度)。
3.结果观察和报告
挑选符合下列特征的菌落进行革兰氏染色、镜检。
紫红色,具有金属光泽的菌落;深红色,不带或略带金属光泽的菌落;淡红色,中心色较深的菌落。如图1

图1 大肠菌群在品红亚硫酸钠培养基上的特征
凡系革兰氏阴性无芽孢杆菌,需再接种于乳糖蛋白胨培养液或乳糖蛋白胨半固体培养基(接种前应将此培养基放入水浴中煮沸排气,冷却凝固后方能使用),经37℃培养,前者于24 h产酸产气,如图2;或后者经6 h~8 h培养后产气,如图3,则判为总大肠菌群阳性。

图2 大肠菌群在乳糖蛋白胨培养液中的阳性情况

图3 不同细菌在乳糖蛋白胨半固体培养基上的生长特征
计数滤膜上生长的大肠菌群菌落总数,根据过滤的水样量计算1 L水样中总大肠菌群
|
总大肠菌群数(CFU/L)= |
滤膜上生长的大肠杆菌菌落数*1000 |
|
过滤水样量(mL) |
滤膜上菌落数以20 CFU-60 CFU/片较为适宜。
二、相关培养基的采购
球盟会(中国)网页版有适用于水中大肠菌群检验的相关培养基,客户可根据实际情况和用途进行选用。
|
产品编号 |
产品名称 |
规格 |
产品说明及用途 |
|
HB0118 |
250g |
用于饮用水和水源水中总大肠菌群的选择性分离和确证(GB标准) |
|
|
HB0119 |
250g |
用于饮用水,水源水中总大肠菌群的测定 |
|
|
HBPT009 |
10mL*20支/盒 |
用于大肠菌群、大肠杆菌的测定 |
|
|
HB8463 |
250g |
用于饮用水和水源水中大肠菌群的测定试验 |
注:本文属海博生物原创,未经允许不得转载。
下一篇:微生物如何塑造食物的风味
| 相关文章: | ||



